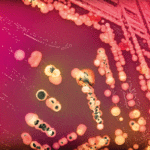
Something in the air

Measuring methane at landfill sites using drones
Waste management firm Viridor says it is demonstrating its ambition to tackle climate change by supporting the development of new technologies for measuring and...
Gas sensor network provides early wildfire detection
A large-scale IoT network for the ultra-early detection of wildfires has been launched by environmental startup Dryad Networks. The first live demonstration of the...
Sponsored Content: Lead-time leadership claim in gas sensing
Ensuring that products reach customers on time is a critical part of any business, but more so for those who deal in products designed to help keep workplaces and staff safe. As global leaders in the development, manufacturing, and distribution of gas detection instruments, Ion Science are all too aware of the need to get product to customers on time. Their team have dedicated significant time and resource to creating a network of reliable distributors around the globe, supported by knowledgeable technical staff.
Sponsored Content: Monitoring multiple gases simultaneously
The UK-based continuous emission monitoring and process analyser manufacturing company Protea. has announced two new ranges to its portfolio.
Sponsored Content: High flow pump simplifies asbestos and air sampling
Asbestos-related diseases take the lives of more than 39,000 Americans every year. Despite the material’s known health impacts, it can be found in older homes and industrial properties and continues to be used in products such as gaskets, friction products, roofing materials and fireproofing materials, posing a threat to workers in construction and general industry.
Something in the air
Scientists at Ben-Gurion University of the Negev (BGU) say they have invented an artificial nose equipped to perform continuous bacterial monitoring - a capability they say has never previously been achieved and one with multiple applications in medicine, environmental monitoring and food.
Sensitive methane sensing on a budget?
Researchers from Princeton University and the US Naval Research Laboratory have demonstrated a new gas sensor, which uses an interband cascade light emitting device (ICLED) to detect methane concentrations as low as 0.1 ppm
Pandemic air quality due to weather, not just lockdowns
Headlines proclaiming Covid lockdowns drastically reduced pollution were mostly referring to nitrogen dioxide, NO2, a reactive gas emitted from burning fuel
A new level of magnification?
Experiments using crystalline "supermirrors" at the University of Vienna promise to open up entirely new possibilities for trace gas detection in environmental science and medicine
Low-cost air quality monitors included in education packs for schoolchildren
Clean Air Day (17th June) was marked by hundreds of events across the UK.
Fife Council and sustainability consultancy Ricardo have provided three Scottish...
Sponsored Content: A new level of enhanced, reliable protection against VOCs
Offering a new level of enhanced, reliable protection against VOCs with the first 11.7 Cub personal solution from ION Science
In a 2018 report...
Sponsored content: Hire management just got easier
Reinforcing Casella’s engineering expertise and experience producing quality monitoring instruments, the Casella Guardian2 can help control site emissions and reduce environmental risks. Casella has introduced new features to make hire management easier.
Sponsored content: Portable VOC detector scores on carbon and employee hygiene
Thanks to a patented photoionisation detection (PID) system for volatile organic compounds (VOCs), UK based gas detection manufacturing expert ION Science is helping employers significantly reduce the daily exposure risks faced by occupational hygienists and technicians operating in the chemical or petrochemical industries.
Environmental hazard monitoring expert announces 2021 webinar series for dust, noise, vibration and asbestos...
Global occupational health and workplace hazard monitoring expert Casella has announced its schedule of webinars for 2021. The line-up of free-to-attend, virtually accessible webinars...
Protecting sensitive buildings from the effects of climate change
Instrumentation firm Vaisala writes
The Sigrid Jusélius mausoleum was built in 1901-03 and is a significant cultural site in Finland. With sandstone walls and interiors...
Prevention: A profitable mindset when it comes to gas leaks
Gas leaks are a risk in many industries, and when they occur, they can be incredibly hazardous and costly. Preventing them and responding quickly...
Solar tech sniffs out chemical agents
In a colourful solution to a dangerous problem, Australian scientists are adapting a component from cutting-edge solar cells to design a rapid, light-based detection system for deadly toxins
Probe helps optimise biogas upgrading
Finnish firm Vaisala has launched a new instrument for off-gas methane and carbon dioxide measurements in the biomethane production process
Monitoring solvent emissions
VOCs are released from industrial activities that utilise organic chemicals such as solvents, as well as from engines and incinerators that burn organic materials and fuels. Both types of application present similar monitoring requirements.
Scientists adapt solar energy technology to detect chemical warfare agents and pesticides
Researchers are harnessing next-generation photovoltaics materials to create a fast, accurate testing mechanism for harmful compounds
In a colourful solution to a dangerous problem, Australian...